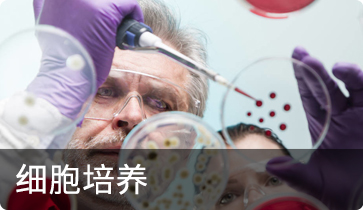
圖片標題

生命科學類
采用經驗證的細胞培養儀器和設備推進您的研究,包括細胞培養箱、生物安全柜、通用離心機、實驗室冷藏冰箱和冰柜、自動細胞計數儀和細胞成像系統等。
提供智能且易于操作的低溫存儲系統,以及用于高質量樣品存儲的各種低溫儲存器具產品與附件。
提供一系列細胞分析研究解決方案,包標記與檢測技術、抗體與免疫檢測、細胞成像系統、自動細胞計數儀以及 聲波聚焦流式細胞儀。
除性能優異的光學/離子和電子顯微鏡外,還包括各類熒光光學切片系統及高分辨率 x 射線顯微鏡。
我們提供的產品可幫助您在幾乎任何應用中成功完成PCR實驗。借助值得信賴的熱循環儀和實時PCR系統,您會找到有助于成功進行PCR所需的一切。
我們提供專利的細胞分選技術,簡單易用,表現出色。
版權所有? 2019-2024 :杰晟集團
品牌認證
2294天
已認證